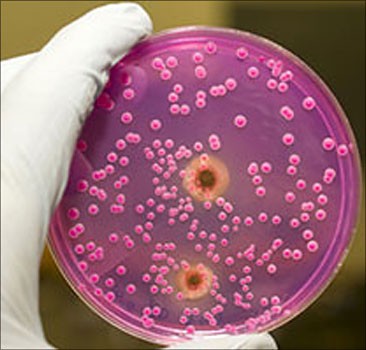
Грибки кандида

Дрожжевой стоматит (кандидоз) – это грибковое заболевание слизистых оболочек. Вызывают это заболевание дрожжеподобные грибы рода Candida. Они живут у всех людей в полости рта и являются условно-патогенными микроорганизмами, т.е. безвредными до поры до времени. При определенных условиях (например, снижение иммунитета) они могут становиться патогенными и вызывать воспаление.
Дрожжевой стоматит часто возникает у ослабленных детей первых недель жизни. Также могут болеть и здоровые дети, которые плохо чистят зубы.
Симптомы дрожжевого стоматита
Как проявляется грибковый стоматит? Наиболее часто он встречается в полости рта. На покрасневшей слизистой оболочке чаще языка, реже щёк по линии смыкания зубов, появляются белые налеты, которые напоминают «творожистые массы». Налёт этот легко снимается, обнажая гладкую, отёчную поверхность. В тяжелых случаях налёт соскабливается с трудом, обнажая эрозивную кровоточащую поверхность.


Налет при дрожжевом стоматите
Жалобы могут быть на сухость, жжение в полости рта, извращение вкуса. У маленьких детей возможно повышение температуры тела. Ребенок плохо кушает, может совсем отказываться от еды. Может беспокойно спать.
В тяжёлых случаях грибы Candida могут поражать слизистые оболочки влагалища и половых губ у девочек, половые органы у мальчиков.
При постановке диагноза дрожжевого стоматита учитываются типичные жалобы, клиническая картина, данные лабораторных исследований (проводят микроскопическое исследование материла, взятого с поверхности слизистой оболочки полости рта). Соскоб нужного материала для исследования необходимо делать утром натощак, чистить зубы и полоскать рот при этом не нужно.
Грибки кандида
Как можно заразиться ребёнку дрожжевым стоматитом?
- при рождении естественным путём, если у мамы ребёнка была грибковая инфекция в половых путях;
- в период кормления грудью (в том случае, если у мамы есть трещины на сосках, и в них «поселились» дрожжевые грибы);
- при ослабленном иммунитета.
Традиционное лечение дрожжевого стоматита
Лечение стоматита проводит врач - стоматолог. Но если грибок затронул слизистые оболочки других органов, следует обратиться к педиатру.
Важно в полости рта создать щелочную среду, это нужно для предотвращения размножения грибов и уменьшения их количества. Для этого, перед и после еды, каждый раз необходимо прополоскать рот раствором пищевой соды. Маленьким детям, которые не умеют полоскать рот самостоятельно, следует протирать язык и щёки стерильной марлей, смоченной в содовом растворе (на стакан кипячёной воды десертная ложка соды) или йодной воде.
Препараты йода можно также использовать для обработки слизистой оболочки полости рта. Делать полоскания кипяченой тёплой водой с добавлением йода (на полстакана воды 6 -12 капель йода) 3- 5 раз в день.
Важно соблюдение гигиены полости рта - чистить зубы 2 раза в день, очищать язык от налёта, специальными для этого приспособлениями (скребок для чистки языка).
Если симптомы грибкового стоматита не проходят, то назначают противогрибковые мази, гели или таблетки для рассасывания во рту. Обычно это Нистатин, драже Декамин. Лечение следует продолжать в течение 5 – 10 дней, даже после полного исчезновения налёта на языке, щеках, во избежание рецидива заболевания.
Важно знать и помнить, что невылеченные кариозные зубы являются хорошим «местом для жизни» грибов и причиной повторного инфицирования кандидозом. Поэтому важно вылечить все больные зубы сразу после их обнаружения.
Диета ребенка при дрожжевом стоматите
Важно исключить из питания ребёнка во время болезни всё сладкое, в «сладкой» среде дрожжевые грибы очень хорошо размножаются. Не давать ребёнку полуфабрикаты, продукты с различными искусственными красителями и консервантами. Рацион питания должен содержать большое количество витаминов, особенно важно достаточное поступление витамина С. Пища должна быть щадящей, измельченной, не горячей и не холодной, а теплой. Ребёнок должен много пить воды.
Целесообразно включить в рацион питания больного грибковым стоматитом ребёнка цельнозерновые каши, сваренные на молоке или воде, но без добавления сахара. Будет полезен овсяный кисель, несладкие кисломолочные продукты.
Овсяный кисель можно приготовить самостоятельно. Полтора стакана овсянки насыпать в трехлитровую банку и залить её 2 литрами тёплой кипяченой воды, перемешать. Затем необходимо прикрыть горло банки марлей и поставить в теплое место на две суток. По истечении этого времени (два дня) готовую смесь процедить через сложенную в 3 слоя марлю. Полученную жидкость поставить на один день в холодильник. А осадок, который образовался на дне банки, можно будет использовать для приготовления ещё одной порции киселя. Такой осадок является своего рода сывороткой. Для употребления её следует разбавлять водой в соотношении 1:2 и доводить до кипения. Пить полученный овсяный кисель нужно в охлажденном виде.
Лечение дрожжевого стоматита народными средствами
Лечение дрожжевого стоматита народными средствами является хорошей альтернативой традиционным методам лечения, особенно у маленьких детей.
Лечение дрожжевого стоматита у грудных детей
У грудных детей для снятия воспаления и уменьшения болевых ощущений можно использовать настой ромашки или календулы. Для его приготовления нужна 1 столовая ложка цветков и 200 мл кипятка. Цветки залить кипятком и настаивать в течение 1 часа. Применять для полосканий и обработки ротовой полости.
Для ускорения эпитализации (заживления) также можно использовать растительные препараты – масло облепихи, шиповника, персика, сок каланхоэ. Все манипуляции надо проводить очень осторожно, чтобы не навредить малышу и не нанести ему травму.
Для грудных детей источник полезных питательных веществ, профилактическое и лечебное средство против молочницы — морковный сок. Грудного ребенка начинать поить морковным соком с 4-й месяца жизни по 1-2 капли 1 раз в день или через день за 10-15 минут до кормления грудью, постепенно увеличивая количество сока.
Лечение кандидоза у детей старшего возраста немного легче и проще, так как выбор допустимых к использованию лекарственных средств шире.
Полоскания при дрожжевом стоматите:
- Свежеприготовленный сок моркови смешать в равных частях с тёплой водой. Полоскать полость рта 2-4 раза в день.
- Свежеприготовленный сок капусты смешать в равных частях с тёплой водой. Полоскать полость рта 2-4 раза в день.
- Настой липового цвета с содой. 1 ст.л. цветков липы настоять в 1 стакане холодной кипячёной воды в течение 5 часов. Добавить в настой 5 гр. Соды. Поласкать 5-6 раз в день.
- Для уменьшения болезненности полость рта можно полоскать разбавленной водой 3% перекисью водорода (1 чайная ложка перекеси на полстакана кипячёной охлаждённой воды).
- Цветки календулы (1 столовая ложка) залить стаканом кипятка. Укутать и настоять в течение часа, затем процедить. Обрабатывать рот ребенка 2-3 раза в день.
- Траву вербейника обыкновенного (1 столовая ложка) залить стаканом кипятка. Укутать и настоять в течение часа, процедить. Смазывать ребенку поражённые участки во рту.
Есть рецепты народной медицины, в которых в отжатый сок моркови рекомендуют добавлять мёд и смазывать рот ребенку. А также протирать пораженные места тампоном, смоченным в растворе сахара. Следует помнить, что такое лечение может только навредить. Ведь сахар ускоряет размножение грибов рода Candida, следовательно, усиливает жжение, сухость и другие симптомы молочницы.
Врач Мащенок Ю.В.

Комментарии
доктор на приёме выписала лишь протирание полости рта содовым раствором с витамином В12,и 1 т.Нистатина..но за 5 дней улучшений никаких..скорее -наоборот..спас ибо за полезные советы,доктор!! попробуем овсяный кисель!и опять же протирание содовым раствором..